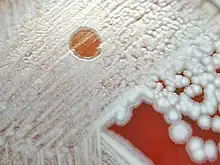

Phage therapy, viral phage therapy, or phagotherapy is the therapeutic use of bacteriophages for the treatment of pathogenic bacterial infections.[1][2][3] This therapeutic approach emerged at the beginning of the 20th century but was progressively replaced by the use of antibiotics in most parts of the world after the Second World War. Bacteriophages, known as phages, are a form of virus[4] that attach to bacterial cells and inject their genome into the cell.[5] The bacteria's production of the viral genome interferes with its ability to function, halting the bacterial infection.[5] The bacterial cell causing the infection is unable to reproduce and instead produces additional phages.[4] Phages are very selective in the strains of bacteria they are effective against.[5]
Advantages include reduced side effects and reduced risk of the bacterium developing resistance, since[5] bacteriophages are much more specific than antibiotics. They are typically harmless not only to the host organism but also to other beneficial bacteria, such as the gut microbiota, reducing the chances of opportunistic infections.[6] They have a high therapeutic index; that is, phage therapy would be expected to give rise to few side effects, even at higher-than-therapeutic levels.[7] Because phages replicate in vivo (in cells of living organism), a smaller effective dose can be used.[8]
Disadvantages include the difficulty of finding an effective phage for a particular infection; a phage will kill a bacterium only if it matches the specific strain.[5] However, virulent phages can be isolated much more easily than other compounds and natural products.[8] Consequently, phage mixtures ("cocktails") are sometimes used to improve the chances of success.[9] Alternatively, samples taken from recovering patients sometimes contain appropriate phages that can be grown to cure other patients infected with the same strain.[10] Ongoing challenges include the need to increase phage collections from reference phage banks, the development of efficient phage screening methods for the fast identification of the therapeutic phage(s), the establishment of efficient phage therapy strategies to tackle infectious biofilms, the validation of feasible phage production protocols that assure quality and safety of phage preparations, and the guarantee of stability of phage preparations during manufacturing, storage, and transport.
Phages tend to be more successful than antibiotics where there is a biofilm covered by a polysaccharide layer, which antibiotics typically cannot penetrate.[11] Phage therapy can disperse the biofilm generated by antibiotic-resistant bacteria.[12] However, the interactions between phages and biofilms can be complex, with phages developing symbiotic as well as predatory relationships with biofilms.[9]
Phages are currently being used therapeutically to treat bacterial infections that do not respond to conventional antibiotics,[2][1][13] particularly in Russia[14] and Georgia.[15][16][17] There is also a phage therapy unit in Wrocław, Poland, established in 2005, which continues several-decades-long research by the Institute of Immunology and Experimental Therapy of the Polish Academy of Sciences, the only such centre in a European Union country.[18] Phages are the subject of renewed clinical attention in Western countries, such as the United States. In 2019, the United States Food and Drug Administration approved the first US clinical trial for intravenous phage therapy.[19]
Phage therapy has many potential applications in human medicine as well as dentistry, veterinary science, and agriculture.[20] If the target host of a phage therapy treatment is not an animal, the term "biocontrol" (as in phage-mediated biocontrol of bacteria) is usually employed, rather than "phage therapy".[9]
History

The discovery of bacteriophages was reported by British bacteriologist Frederick Twort in 1915[21] and by French microbiologist Felix d'Hérelle in 1917.[22][23] D'Hérelle said that the phages always appeared in the stools of Shigella dysentery patients shortly before they began to recover.[24] He "quickly learned that bacteriophages are found wherever bacteria thrive: in sewers, in rivers that catch waste runoff from pipes, and in the stools of convalescent patients".[25] Phage therapy was immediately recognized by many to be a key way forward for the eradication of pathogenic bacterial infections. A Georgian, George Eliava, was making similar discoveries. He travelled to the Pasteur Institute in Paris, where he met d'Hérelle, and in 1923, he founded the George Eliava Institute in Tbilisi, Georgia, devoted to the development of phage therapy. Phage therapy is used in Russia,[26] Georgia and Poland, and was used prophylactically for a time in the Soviet army.
In Russia, extensive research and development soon began in this field. In the United States during the 1940s, commercialization of phage therapy was undertaken by Eli Lilly and Company.[27]
While knowledge was being accumulated regarding the biology of phages and how to use phage cocktails correctly, early uses of phage therapy were often unreliable.[28] Since the early 20th century, research into the development of viable therapeutic antibiotics had also been underway, and by 1942, the antibiotic penicillin G had been successfully purified and saw use during the Second World War. The drug proved to be extraordinarily effective in the treatment of injured Allied soldiers whose wounds had become infected. By 1944, large-scale production of penicillin had been made possible, and in 1945, it became publicly available in pharmacies. Due to the drug's success, it was marketed widely in the US and Europe, leading Western scientists to mostly lose interest in further use and study of phage therapy for some time.[29]
Isolated from Western advances in antibiotic production in the 1940s, Russian scientists continued to develop already successful phage therapy to treat the wounds of soldiers in field hospitals. During World War II, the Soviet Union used bacteriophages to treat soldiers infected with various bacterial diseases, such as dysentery and gangrene.[30] Russian researchers continued to develop and to refine their treatments and to publish their research and results. However, due to the scientific barriers of the Cold War, this knowledge was not translated and did not proliferate across the world.[31][32] A summary of these publications was published in English in 2009 in "A Literature Review of the Practical Application of Bacteriophage Research".[33]
There is an extensive library and research center at the George Eliava Institute in Tbilisi, Georgia. Phage therapy is today a widespread form of treatment in that region.[34]
As a result of the development of antibiotic resistance since the 1950s and an advancement of scientific knowledge, there has been renewed interest worldwide in the ability of phage therapy to eradicate bacterial infections and chronic polymicrobial biofilm (including in industrial situations).[35]
Phages have been investigated as a potential means to eliminate pathogens like Campylobacter in raw food[36] and Listeria in fresh food or to reduce food spoilage bacteria.[37] In agricultural practice, phages have been used to fight pathogens like Campylobacter, Escherichia, and Salmonella in farm animals, Lactococcus and Vibrio pathogens in fish aquaculture, and Erwinia, Xanthomonas, and others in plants of agricultural importance.[38][39][40] The oldest use is, however, in human medicine. Phages have been used against diarrheal diseases caused by E. coli, Shigella, or Vibrio and against wound infections caused by facultative pathogens of the skin like staphylococci and streptococci. Recently, the phage therapy approach has been applied to systemic and even intracellular infections, and non-replicating phage and isolated phage enzymes like lysins have been added to the antimicrobial arsenal. However, actual proof for the efficacy of these phage approaches in the field or the hospital is not available.[37]
Some of the interest in the West can be traced back to 1994, when James Soothill demonstrated (in an animal model) that the use of phages could improve the success of skin grafts by reducing the underlying Pseudomonas aeruginosa infection.[41] Recent studies have provided additional support for these findings in the model system.[42]
Although not "phage therapy" in the original sense, the use of phages as delivery mechanisms for traditional antibiotics constitutes another possible therapeutic use.[43][44] The use of phages to deliver antitumor agents has also been described in preliminary in vitro experiments for cells in tissue culture.[45]
In June 2015, the European Medicines Agency hosted a one-day workshop on the therapeutic use of bacteriophages,[46] and in July 2015, the US National Institutes of Health hosted a two-day workshop titled "Bacteriophage Therapy: An Alternative Strategy to Combat Drug Resistance".[47]
In January 2016, phages were used successfully at Yale University by Benjamin Chan to treat a chronic Pseudomonas aeruginosa infection in ophthalmologist Ali Asghar Khodadoust.[48] This successful treatment of a life-threatening infection sparked a resurgence of interest in phage therapy in the United States.
In 2017, a pair of genetically engineered phages along with one naturally occurring (so-called "phage Muddy") each from among those catalogued by SEA-PHAGES (Science Education Alliance-Phage Hunters Advancing Genomics and Evolutionary Science) at the Howard Hughes Medical Institute by Graham Hatfull and colleagues, was used by microbiologist James Soothill at Great Ormond Street Hospital for Children in London to treat an antibiotic-resistant bacterial (Mycobacterium abscessus) infection in a young woman with cystic fibrosis.[49][50][51][52]
In 2022, two mycobacteriophages were administered intravenously twice daily to a young man with treatment-refractory Mycobacterium abscessus pulmonary infection and severe cystic fibrosis lung disease.[53] Airway cultures for M. abscessus became negative after approximately 100 days of combined phage and antibiotic treatment, and a variety of biomarkers confirmed the therapeutic response. The individual received a bilateral lung transplant after 379 days of treatment, and cultures from the explanted lung tissue confirmed eradication of the bacteria.[53] In a second case, successful treatment of disseminated cutaneous Mycobacterium chelonae was reported with a single phage administered intravenously twice daily in conjunction with antibiotic and surgical management.[54]
Potential benefits

Bacteriophage treatment offers a possible alternative to conventional antibiotic treatments for bacterial infection.[55] It is conceivable that, although bacteria can develop resistance to phages, the resistance might be easier to overcome than resistance to antibiotics.[56][57] Viruses, just like bacteria, can evolve resistance to different treatments.[58]
Bacteriophages are very specific, targeting only one or a few strains of bacteria.[59] Traditional antibiotics have a more wide-ranging effect, killing both harmful and useful bacteria, such as those facilitating food digestion.[60] The species and strain specificity of bacteriophages makes it unlikely that harmless or useful bacteria will be killed when fighting an infection.[61]
A few research groups in the West are engineering a broader-spectrum phage and also a variety of forms of MRSA treatments, including impregnated wound dressings, preventative treatment for burn victims, and phage-impregnated sutures.[62][57] Enzybiotics are a new development at Rockefeller University that create enzymes from phages. Purified recombinant phage enzymes can be used as separate antibacterial agents in their own right.[63]
Phage therapy also has the potential to prevent or treat infectious diseases of corals. This could mitigate the global coral decline.[64]
Applications
Collection
Phages for therapeutic use can be collected from environmental sources that likely contain high quantities of bacteria and bacteriophages, such as effluent outlets, sewage, or even soil.[15] The samples are taken and applied to bacterial cultures that are to be targeted. If the bacteria die, the phages can be grown in liquid cultures.[10]
Modes of treatment
Phages are "bacterium-specific", and therefore, it is necessary in many cases to take a swab from the patient and culture it prior to treatment. Occasionally, isolation of therapeutic phages can require a few months to complete, but clinics generally keep supplies of phage cocktails for the most common bacterial strains in a geographical area.
Phage cocktails are sold in pharmacies in Eastern countries.[65][66] The composition of bacteriophagic cocktails has been periodically modified to add phages effective against emerging pathogenic strains.[67]
Phages in practice are applied orally, topically on infected wounds or spread onto surfaces, or during surgical procedures. Injection is rarely used, avoiding any risks of trace chemical contaminants that may be present from the bacteria amplification stage, and recognizing that the immune system naturally fights against viruses introduced into the bloodstream or lymphatic system.
Reviews of phage therapy indicate that more clinical and microbiological research is needed to meet current standards.[68]
Clinical trials
Funding for phage therapy research and clinical trials is generally insufficient and difficult to obtain, since it is a lengthy and complex process to patent bacteriophage products. An official view is that the effectiveness of each individual phage would need to be demonstrated separately, because administering them in combinations would be too complicated. Due to the specificity of phages, phage therapy would be most effective as a cocktail injection, a modality generally rejected by the US Food and Drug Administration (FDA). Therefore, researchers and observers have predicted that if phage therapy is to gain traction, the FDA must change its regulatory stance on combination drug cocktails.[6] Public awareness and education about phage therapy are generally limited to scientific or independent research rather than mainstream media.[69]
In 2007, phase-1 and 2 clinical trials were completed at the Royal National Throat, Nose and Ear Hospital, London, for Pseudomonas aeruginosa infections (otitis).[70][71][72][73] Phase-1 clinical trials were conducted at the Southwest Regional Wound Care Center of Lubbock, Texas, for a cocktail of phages against P. aeruginosa, Staphylococcus aureus, and Escherichia coli, developed by Intralytix.[74] PhagoBurn, a phase-1 and 2 trial of phage therapy against P. aeruginosa wound infection in France and Belgium in 2015–17, was terminated early due to lack of effectiveness.[75]
Locus Biosciences has created a cocktail of three CRISPR-modified phages. A 2019 study examined its effectiveness against E. coli in the urinary tract,[76] and a phase-1 trial was completed shortly before March 2021.[77] In February 2019, the FDA approved the first clinical trial of intravenously administered phage therapy in the United States.[78]
In July 2020, the FDA approved the first clinical trial of nebulized phage therapy in the United States.[79] This double-blind, placebo-controlled study at Yale University will be focused on treating P. aeruginosa infections in patients with cystic fibrosis.
In February 2020, the FDA approved a clinical trial to evaluate bacteriophage therapy in patients with urinary tract infections.[80] The study started in December 2020 and aims to identify ideal bacteriophage treatment regimens based on improvements in disease control rates.
In February 2021, the FDA approved a clinical trial to evaluate bacteriophage therapy in patients with chronic prosthetic joint infections (PJI).[81] The study was to begin in October 2022 and be conducted by Adaptive Phage Therapeutics, in collaboration with the Mayo Clinic.
Administration
Phages can usually be freeze-dried and turned into pills without materially reducing efficiency.[15] Temperature stability up to 55 °C and shelf lives of 14 months have been shown for some types of phages in pill form.[15] Application in liquid form is possible, stored preferably in refrigerated vials.[15] Oral administration works better when an antacid is included, as this increases the number of phages surviving passage through the stomach.[15] Topical administration often involves application to gauzes that are laid on the area to be treated.[15]
Successful treatments
Phages were used successfully at Yale University by Benjamin Chan to treat a Pseudomonas infection in 2016.[48] Intravenous phage drip therapy was successfully used to treat a patient with multidrug-resistant Acinetobacter baumannii in Thornton Hospital at UC San Diego in 2017.[82] Nebulized phage therapy has been used successfully to treat numerous patients with cystic fibrosis and multidrug-resistant bacteria at Yale University as part of their compassionate use program.[83][84] In 2019, a Brownsville, Minnesota resident with a longstanding bacterial infection in his knee received a phage treatment at the Mayo Clinic that eliminated the need for amputation of his lower leg.[85] Individualised phage therapy was also successfully used by Robert T. Schooley and others to treat a case of multi-drug-resistant Acinetobacter baumannii in 2015.[86][87] In 2022, an individually adjusted phage-antibiotic combination as an antimicrobial resistance treatment was demonstrated and described in detail.[88][89] The scientists called for scaling up the research[90] and for further development of this approach.[91]
Treatment of biofilm infections

Phage therapy is being used to great effect in the treatment of biofilm infections, especially Pseudomonas aeruginosa and Staphylococcus aureus.[92][93] From 78 recent cases of treatment of biofilm infections, 96% of patients saw clinical improvement using phage therapy, and 52% of patients saw complete symptom relief or a full expungement of the affecting bacteria.[92] Biofilm infections are very challenging to treat with antibiotics. The biofilm matrix and surrounding bacterial membranes can bind to the antibiotics, preventing them from penetrating the biofilm. The matrix may contain enzymes that deactivate antibiotics. Biofilms also have low metabolic activity, which means antibiotics that target growing processes have much lower efficacy. These factors make phage therapy an enticing option for the treatment of such infections, and there are currently two ways to go about such treatment. The first is to isolate the initial bacteria and make a specific treatment phage to target it, while the second way is to use a combination of more general phages.[93] The advantage of the second method is that it can easily be made commercially available for treatment, although there are some concerns that it may be substantially less effective.[92]

Limitations
The high bacterial strain specificity of phage therapy may make it necessary for clinics to make different cocktails for treatment of the same infection or disease, because the bacterial components of such diseases may differ from region to region or even person to person. In addition, this means that "banks" containing many different phages must be kept and regularly updated with new phages.[6]
Further, bacteria can evolve different receptors either before or during treatment. This can prevent phages from completely eradicating them.[15]
The need for banks of phages makes regulatory testing for safety harder and more expensive under current rules in most countries. Such a process would make the large-scale use of phage therapy difficult. Additionally, patent issues (specifically on living organisms) may complicate distribution for pharmaceutical companies wishing to have exclusive rights over their "invention", which would discourage a commercial corporation from investing capital in this.
As has been known for at least thirty years, mycobacteria such as Mycobacterium tuberculosis have specific bacteriophages.[94] No lytic phage has yet been discovered for Clostridium difficile, which is responsible for many nosocomial diseases, but some temperate phages (integrated in the genome, also called lysogenic) are known for this species; this opens encouraging avenues but with additional risks, as discussed below.
The negative public perception of viruses may also play a role in the reluctance to embrace phage therapy.[95]
Development of resistance
One of the major concerns usually associated with phage therapy is the emergence of phage-insensitive mutants (BIMs) that could hinder the success of this therapy. In fact, several in vitro studies have reported a fast emergence of BIMs within a short period of time after phage treatment.[96][97][98] The emergence of BIMs has also been observed in vivo using different animal models, although this usually occurs later than in vitro (reviewed in [99]). This fast adaptation of bacteria to phage attack is usually caused by mutations on genes encoding phage receptors,[97][100] which include lipopolysaccharides (LPS), outer membrane proteins, capsules, flagella, and pili, among others.[101] However, some studies suggest that when phage resistance is caused by mutations in phage receptors, this might result in fitness costs to the resistance bacterium, which will ultimately become less virulent.[99][102] Moreover, it has been shown that the evolution of bacterial resistance to phage attack changes the efflux pump mechanism, causing increased sensitivity to drugs from several antibiotic classes.[103] Therefore, it is conceivable to think that phage therapy that uses phages that exert selection for multidrug-resistant bacteria to become antibiotic-sensitive could potentially reduce the incidence of antibiotic-resistant infections.
Besides the prevention of phage adsorption by loss or modification of bacterial receptors, phage insensitivity can be caused by: (i) prevention of phage DNA entry by superinfection exclusion systems; (ii) degradation of phage DNA by restriction-modification systems or by CRISPR-Cas systems; and (iii) use of abortive infection systems that block phage replication, transcription, or translation, usually in conjunction with suicide of the host cell.[104] Altogether, these mechanisms promote a quick adaptation of bacteria to phage attack and therefore, the emergence of phage-resistant mutants is frequent and unavoidable.
It is still unclear whether the wide use of phages would cause resistance similar to what has been observed for antibiotics. In theory, this is not very likely to occur, since phages are very specific, and therefore, their selective pressure would affect a very narrow group of bacteria. However, we should also consider the fact that many phage resistance systems are mounted on mobile genetic elements, including prophages and plasmids, and thus may spread quite rapidly even without direct selection. Nevertheless, in contrast to antibiotics, phage preparations for therapeutic applications are expected to be developed in a personalized way because of the high specificity of phages. In addition, strategies have been proposed to counter the problem of phage resistance. One of the strategies is the use of phage cocktails with complementary host ranges (different host ranges, which, when combined, result in an overall broader host range) and targeting different bacterial receptors. Another strategy is the combination of phages with other antimicrobials such as antibiotics, disinfectants, or enzymes that could enhance their antibacterial activity. The genetic manipulation of phage genomes can also be a strategy to circumvent phage resistance.
Safety aspects
Bacteriophages are bacterial viruses, evolved to infect bacterial cells. To do that, phages must use characteristic structures at cell surfaces (receptors), and to propagate they need appropriate molecular tools inside the cells. Bacteria are prokaryotes, and their cells differ substantially from eukaryotes, including humans or animals.[105] For this reason, phages meet the major safety requirement: they do not infect treated individuals. Even engineered phages and induced artificial internalization of phages into mammalian cells do not result in phage propagation.[106] Natural transcytosis of unmodified phages, that is, uptake and internal transport to the other side of a cell, which was observed in human epithelial cells, did not result in phage propagation or cell damage.[107] Recently, however, it was reported that filamentous temperate phages of P. aeruginosa can be endocytosed into human and murine leukocytes, resulting in transcription of the phage DNA. In turn, the product RNA triggers maladaptive innate viral pattern-recognition responses and thus inhibits the immune clearance of the bacteria.[108] Whether this also applies to dsDNA phages like Caudovirales has not yet been established; this is an important question to be addressed as it may affect the overall safety of phage therapy.
Due to many experimental treatments in human patients conducted in past decades, and to already existing RCTs (see section: Clinical experience and randomized controlled trials), phage safety can be assessed directly. The first safety trial in healthy human volunteers for a phage was conducted by Bruttin and Brüssow in 2005.[109] They investigated the oral administration of Escherichia coli phage T4 and found no adverse effects of the treatment. Historical record shows that phages are safe, with mild side effects, if any. The most frequent (though still rare) adverse reactions to phage preparations found in patients were symptoms from the digestive tract, local reactions at the site of administration of a phage preparation, superinfections, and a rise in body temperature.[110][28][111] Notably, these reactions may have been (i) due to the liberation of endotoxins from bacteria lysed in vivo by the phages, since such effects also can be observed when antibiotics are used,[112] or (ii) caused by bacterial debris that accompanied the phage in cases where unpurified lysates were used.
Bacteriophages must be produced in bacteria that are lysed (i.e., fragmented) during phage propagation. As such, phage lysates contain bacterial debris that may affect the human organism even when the phage itself is unharmful. For these and other reasons, purification of bacteriophages is considered important, and phage preparations need to be assessed for their safety as a whole, particularly when phages are to be administered intravenously. This is consistent with general procedures for other drug candidates. In 2015, a group of phage therapy experts summarized the quality and safety requirements for sustainable phage therapy.[113]
Phage effects on the human microbiome also contribute to safety issues in phage therapy. It is important to note that many phages, especially temperate ones, carry genes that can affect the pathogenicity of the host. Even lambda, a temperate phage of the E. coli K-12 laboratory strain, carries two genes that provide potential virulence benefits to the lysogenic host, one that increases intestinal adherence and the other that confers resistance to complement killing in the blood. For this reason, temperate phages are generally to be avoided as candidates for phage therapy, although in some cases, the lack of lytic phage candidates and emergency conditions may make such considerations moot.[51] Another potential problem is generalized transduction, a term for the ability of some phages to transfer bacterial DNA from one host to another. This occurs because the systems for packaging of the phage DNA into capsids can mistakenly package host DNA instead. Indeed, with some well-characterized phages, up to 5% of the virus particles contain only bacterial DNA. Thus in a typical lysate, the entire genome of the propagating host is present in more than a million copies in every milliliter. For these reasons, it is imperative that any phage to be considered for therapeutic usage should be subjected to thorough genomic analysis and tested for the capacity for generalized transduction.
As antibacterials, phages may also affect the composition of microbiomes, by infecting and killing phage-sensitive strains of bacteria. However, a major advantage of bacteriophages over antibiotics is the high specificity of bacteriophages. This specificity limits antibacterial activity to a sub-species level; typically, a phage kills only selected bacterial strains. For this reason, phages are much less likely (than antibiotics) to disturb the composition of a natural microbiome or to induce dysbiosis. This was demonstrated in experimental studies where microbiome composition was assessed by next-generation sequencing that revealed no important changes correlated with phage treatment in human treatments.[114][115][116][117][118][119]
Much of the difficulty in obtaining regulatory approval is proving to be the risks of using a self-replicating entity that has the capability to evolve.[35]
As with antibiotic therapy and other methods of countering bacterial infections, endotoxins are released by the bacteria as they are destroyed within the patient (Jarisch–Herxheimer reaction). This can cause symptoms of fever; in extreme cases, toxic shock (a problem also seen with antibiotics) is possible.[120] Janakiraman Ramachandran[121] argues that this complication can be avoided in those types of infection where this reaction is likely to occur by using genetically engineered bacteriophages that have had their gene responsible for producing endolysin removed. Without this gene, the host bacterium still dies but remains intact, because the lysis is disabled. On the other hand, this modification stops the exponential growth of phages, so one administered phage means at most one dead bacterial cell.[17] Eventually, these dead cells are consumed by the normal house-cleaning duties of the phagocytes, which utilize enzymes to break down the whole bacterium and its contents into harmless proteins, polysaccharides, and lipids.[122]
Temperate (or lysogenic) bacteriophages are not generally used therapeutically, since this group can act as a way for bacteria to exchange DNA. This can help spread antibiotic resistance or even, theoretically, make the bacteria pathogenic, such as in cases of cholera. Carl Merril has claimed that harmless strains of corynebacterium may have been converted into C. diphtheriae that "probably killed a third of all Europeans who came to North America in the seventeenth century".[123] Fortunately, many phages seem to be lytic only with negligible probability of becoming lysogenic.[124]
Regulation and legislation
Approval of phage therapy for use in humans has not been given in Western countries, with a few exceptions. In the United States, Washington and Oregon law allows naturopathic physicians to use any therapy that is legal anywhere in the world on an experimental basis,[125] and in Texas, phages are considered natural substances and can be used in addition to (but not as a replacement for) traditional therapy (they have been used routinely in a wound care clinic in Lubbock since 2006).[126]
In 2013, "the 20th biennial Evergreen International Phage Meeting ... conference drew 170 participants from 35 countries, including leaders of companies and institutes involved with human phage therapies from France, Australia, Georgia, Poland, and the United States."[127]
In France, phage therapy disappeared officially with the withdrawal of the Vidal dictionary (France's official drug directory), in 1978. The last phage preparation, produced by l'Institut du Bactériophage, was an ointment against skin infections. Phage therapy research ceased at about the same time across the country, with the closure of the bacteriophage department at the Pasteur Institute. Some hospital physicians continued to offer phage therapy until the 1990s, when production died out.[128]
On their rediscovery, at the end of the 1990s, phage preparations were classified as medicines, i.e., "medicinal products" in the EU or "drugs" in the US.[129] However, the pharmaceutical legislation that had been implemented since their disappearance from Western medicine was mainly designed to cater for industrially-made pharmaceuticals, devoid of any customization and intended for large-scale distribution,[130] and it was not deemed necessary to provide phage-specific requirements or concessions.
Today's phage therapy products need to comply with the entire battery of medicinal product licensing requirements: manufacturing according to GMP, preclinical studies, phase I, II, and III clinical trials, and marketing authorisation. Technically, industrially produced predefined phage preparations could make it through the conventional pharmaceutical processes, minding some adaptations. However, phage specificity and resistance issues are likely to cause these defined preparations to have a relatively short useful lifespan.[131] The pharmaceutical industry is currently not considering phage therapy products. Yet, a handful of small and medium-sized enterprises have shown interest, with the help of risk capital and/or public funding. Currently, no defined therapeutic phage product has made it to the EU or US markets.

According to some, therapeutic phages should be prepared individually and kept in large phage banks, ready to be used, upon testing for effectiveness against the patient's bacterial pathogen(s). Intermediary or combined (industrially made as well as precision phage preparations) approaches could be appropriate.[131] However, it turns out to be difficult to reconcile classical phage therapy concepts, which are based on the timely adaptation of phage preparations, with current Western pharmaceutical R&D and marketing models. Repeated calls for a specific regulatory framework have not been heeded by European policymakers.[130] A phage therapy framework based on the Biological Master File concept has been proposed as a (European) solution to regulatory issues, but European regulations do not allow for an extension of this concept to biologically active substances such as phages.[132]
Meanwhile, representatives from the medical, academic, and regulatory communities have established some (temporary) national solutions. For instance, phage applications have been performed in Europe under the umbrella of Article 37 (Unproven Interventions in Clinical Practice) of the Helsinki Declaration. To enable the application of phage therapy after Poland had joined the EU in 2004, the Ludwik Hirszfeld Institute of Immunology and Experimental Therapy in Wrocław opened its own Phage Therapy Unit (PTU). Phage therapy performed at the PTU is considered an "experimental treatment", covered by the adapted Act of 5 December 1996 on the Medical Profession (Polish Law Gazette, 2011, No. 277 item 1634) and Article 37 of the Helsinki Declaration.[133] Similarly, in the last few years, a number of phage therapy interventions have been performed in the US under the FDA's emergency Investigational New Drug (eIND) protocol.[134]
Some patients have been treated with phages under the umbrella of "compassionate use", which is a treatment option that allows a physician to use a not-yet-authorized medicine in desperate cases. Under strict conditions, medicines under development can be made available for use in patients for whom no satisfactory authorized therapies are available and who cannot participate in clinical trials. In principle, this approach can only be applied to products for which earlier study results have demonstrated efficacy and safety, but have not yet been approved. Much like Article 37 of the Helsinki Declaration, the compassionate use treatment option can only be applied when the phages are expected to help in life-threatening or chronic and/or seriously debilitating diseases that are not treatable with formally approved products.
In France, ANSM, the French medicine agency, has organized a specific committee—Comité Scientifique Spécialisé Temporaire (CSST)—for phage therapy, which consists of experts in various fields. Their task is to evaluate and guide each phage therapy request that ends up at the ANSM. Phage therapy requests are discussed together with the treating physicians and consensus advice is sent to the ANSM], which then decides whether or not to grant permission. Between 2006 and 2018, fifteen patients were treated in France (eleven recovered) using this pathway.[135]
In Belgium, in 2016 and in response to a number of parliamentary questions, Maggie De Block, the Minister of Social Affairs and Health, acknowledged that it is indeed not evident to treat phages as industrially made drugs, and therefore she proposed to investigate if the magistral preparation pathway could offer a solution.[131] Magistral preparations (compounding pharmacies in the US) are not subjected to certain constraints such as GMP compliance and marketing authorization. As the "magistral preparation framework" was created to allow for adapted patient treatments and/or to use medicines for which there is no commercial interest, it seemed a suitable framework for precision phage therapy concepts. Magistral preparations are medicines prepared in a pharmacy in accordance with a medical prescription for an individual patient. They are made by a pharmacist (or under his/her supervision) from their constituent ingredients, according to the technical and scientific standards of pharmaceutical technology. Phage active pharmaceutical ingredients to be included in magistral preparations must meet the requirements of a monograph, which describes their production and quality control testing. They must be accompanied by a certificate of analysis, issued by a "Belgian Approved Laboratory", which has been granted an accreditation to perform batch-release testing of medicinal products. Since 2019, phages have been delivered in the form of magistral preparations to nominal patients in Belgium.[136]
The first phage therapy case in China can be traced back to 1958, at Shanghai Jiao Tong University School of Medicine.[137] However, many regulations were not yet established back then, and phage therapy soon lost people's interest due to the prevalence of antibiotics, which eventually led to the antimicrobial resistance crisis. This prompted researchers in China as well as the Chinese government to pay attention to phage therapy again, and following the first investigator-initiated trial (IIT) by the Shanghai Institute of Phage in 2019, phage therapy rapidly flourished.[138] Currently, commercial phage therapy applications must go through either one of two pathways. The first is for fixed-ingredient phage products.[139] The second pathway is for personalized phage products, which need to go through IITs. This way, the products are considered restrictive medical technologies.[140]
Application in other species
Animals
Phage therapy has been a relevant mode of treatment in animals for decades.[141] It has been proposed as a method of treating bacterial infections in the veterinary medical field in response to the rampant use of antibiotics. Studies have investigated the application of phage therapy in livestock species as well as companion animals.[142] Brigham Young University has been researching the use of phage therapy to treat American foulbrood in honeybees.[143][144][145] Phage therapy is also being investigated for potential applications in aquaculture.[146]
Plants
Phage therapy has been studied for bacterial spot of stonefruit, caused by Xanthomonas pruni (syn. X. campestris pv. pruni, syn. X. arboricola pv. pruni) in prunus species.[147][40] Some treatments have been very successful.[147][40]
Cultural impact
The 1925 novel and 1926 Pulitzer Prize winner Arrowsmith by Sinclair Lewis used phage therapy as a plot point.[148][149][150]
Greg Bear's 2002 novel Vitals features phage therapy, based on Soviet research, used to transfer genetic material.
The 2012 collection of military history essays about the changing role of women in warfare, Women in War – From Home Front to Front Line includes a chapter featuring phage therapy: "Chapter 17: Women who thawed the Cold War".[151]
Steffanie A. Strathdee's book The Perfect Predator: An Epidemiologist's Journey to Save Her Husband from a Deadly Superbug, co-written with her husband, Thomas Patterson, was published by Hachette Book Group in 2019. It describes Strathdee's ultimately successful attempt to introduce phage therapy as a life-saving treatment for her husband, critically ill with a completely antibiotic-resistant Acinetobacter baumannii infection following severe pancreatitis.
See also
References
This article was adapted from the following source under a CC BY 4.0 license (2021) (reviewer reports):
Joana Azeredo; Jean-Paul Pirnay; Diana Priscila Pires; Mzia Kutateladze; Krystyna Dabrowska; Rob Lavigne; Bob G Blasdel (15 December 2021), "Phage Therapy" (PDF), WikiJournal of Medicine, WikiJournal of Medicine, 8 (1): 4, doi:10.15347/WJM/2021.004, ISSN 2002-4436, Wikidata Q100400597
- 1 2 Kortright KE, Chan BK, Koff JL, Turner PE (February 2019). "Phage Therapy: A Renewed Approach to Combat Antibiotic-Resistant Bacteria". Cell Host & Microbe. 25 (2): 219–232. doi:10.1016/j.chom.2019.01.014. PMID 30763536. S2CID 73439131.
- 1 2 Gordillo Altamirano FL, Barr JJ (April 2019). "Phage Therapy in the Postantibiotic Era". Clinical Microbiology Reviews. 32 (2). doi:10.1128/CMR.00066-18. PMC 6431132. PMID 30651225.
- ↑ "Silent Killers: Fantastic Phages?". CBS News.
- 1 2 Sulakvelidze A, Alavidze Z, Morris JG (March 2001). "Bacteriophage therapy". Antimicrobial Agents and Chemotherapy. 45 (3): 649–659. doi:10.1128/AAC.45.3.649-659.2001. PMC 90351. PMID 11181338.
- 1 2 3 4 5 "Bacteriophage: A solution to our antibiotics problem? How we can us a virus to fight bacterial infection". Science in the News. 1 February 2018. Retrieved 28 January 2020.
- 1 2 3 Keen EC (2012). "Phage therapy: concept to cure". Frontiers in Microbiology. 3: 238. doi:10.3389/fmicb.2012.00238. PMC 3400130. PMID 22833738.
- ↑ Fernández L, Gutiérrez D, García P, Rodríguez A (August 2019). "The Perfect Bacteriophage for Therapeutic Applications-A Quick Guide". Antibiotics. 8 (3): 126. doi:10.3390/antibiotics8030126. PMC 6783975. PMID 31443585.
- 1 2 Saha D, Mukherjee R (July 2019). "Ameliorating the antimicrobial resistance crisis: phage therapy". IUBMB Life. 71 (7): 781–790. doi:10.1002/iub.2010. PMID 30674079.
- 1 2 3 Pires DP, Melo LD, Azeredo J (September 2021). "Understanding the Complex Phage-Host Interactions in Biofilm Communities". Annual Review of Virology. 8 (1): 73–94. doi:10.1146/annurev-virology-091919-074222. hdl:1822/74528. PMID 34186004.
- 1 2 Hyman P (March 2019). "Phages for Phage Therapy: Isolation, Characterization, and Host Range Breadth". Pharmaceuticals. 12 (1): 35. doi:10.3390/ph12010035. PMC 6469166. PMID 30862020.
- ↑ Aguita M. "Combatting Bacterial Infection". LabNews.co.uk. Archived from the original on 28 February 2009. Retrieved 5 May 2009.
- ↑ Pai L, Patil S, Liu S, Wen F (2023). "A growing battlefield in the war against biofilm-induced antimicrobial resistance: insights from reviews on antibiotic resistance". Front Cell Infect Microbiol. 13: 1327069. doi:10.3389/fcimb.2023.1327069. PMC 10770264. PMID 38188636.
- ↑ González-Mora A, Hernández-Pérez J, Iqbal HM, Rito-Palomares M, Benavides J (September 2020). "Bacteriophage-Based Vaccines: A Potent Approach for Antigen Delivery". Vaccines. 8 (3): 504. doi:10.3390/vaccines8030504. PMC 7565293. PMID 32899720.
- ↑ "Eaters of bacteria: Is phage therapy ready for the big time?". Discover Magazine. 20 May 2011. Retrieved 12 April 2013.
- 1 2 3 4 5 6 7 8 BBC Horizon: Phage — The Virus that Cures 9 October 1997
- ↑ Parfitt T (2005). "Georgia: an unlikely stronghold for bacteriophage therapy". Lancet. 365 (9478): 2166–2167. doi:10.1016/S0140-6736(05)66759-1. PMID 15986542. S2CID 28089251.
- 1 2 Thiel K (January 2004). "Old dogma, new tricks--21st Century phage therapy". Nature Biotechnology. 22 (1): 31–36. doi:10.1038/nbt0104-31. PMID 14704699. S2CID 27108321.
- ↑ "Phage Therapy Unit of the Medical Centre of the Institute of Immunology and Experimental Therapy PAS". Instytut Immunologii i Terapii Doświadczalnej im. Ludwika Hirszfelda Polskiej Akademii Nauk.
- ↑ Jones, Heather (11 January 2019). "First US clinical trial for intravenous phage therapy gets FDA approval". Biotechniques. Retrieved 28 January 2020.
- ↑ "The New Phage Biology: From Genomics to Applications". www.caister.com.
- ↑ Twort FW (1915). "An investigation on the nature of ultra-microscopic viruses". The Lancet. 186 (4814): 1241–1243. doi:10.1016/S0140-6736(01)20383-3.
- ↑ D'Herelle F (1917). "Sur un microbe invisible antagoniste des bacilles dysenteriques" [An invisible microbe that is antagonistic to the dysentery bacillus]. Comptes Rendus (in French). 165: 373–375.
- ↑ Shasha SM, Sharon N, Inbar M (February 2004). "[Bacteriophages as antibacterial agents]". Harefuah (in Hebrew). 143 (2): 121–5, 166. PMID 15143702.
- ↑ Häusler (2006, ch. 1, at the limits of medicine)
- ↑ Kuchment (2012, p. 11)
- ↑ "State Register of Medicines". grls.rosminzdrav.ru. Retrieved 12 September 2023.
- ↑ "Phage 101 – Bacteriophage Therapy". UC Health – UC San Diego. Retrieved 15 March 2022.
- 1 2 Kutter E, De Vos D, Gvasalia G, Alavidze Z, Gogokhia L, Kuhl S, Abedon ST (January 2010). "Phage therapy in clinical practice: treatment of human infections". Current Pharmaceutical Biotechnology. 11 (1): 69–86. doi:10.2174/138920110790725401. PMID 20214609.
- ↑ Hanlon GW (August 2007). "Bacteriophages: an appraisal of their role in the treatment of bacterial infections". International Journal of Antimicrobial Agents. 30 (2): 118–128. doi:10.1016/j.ijantimicag.2007.04.006. PMID 17566713.
- ↑ Summers WC (April 2012). "The strange history of phage therapy". Bacteriophage. 2 (2): 130–133. doi:10.4161/bact.20757. PMC 3442826. PMID 23050223.
- ↑ Stone R (October 2002). "Bacteriophage therapy. Stalin's forgotten cure" (PDF). Science. 298 (5594): 728–731. doi:10.1126/science.298.5594.728. PMID 12399562. S2CID 22395770. Archived from the original (PDF) on 25 June 2016. Retrieved 18 November 2007.
- ↑ Summers WC (2001). "Bacteriophage therapy". Annual Review of Microbiology. 55: 437–451. doi:10.1146/annurev.micro.55.1.437. PMID 11544363.
- ↑ Nina Chanishvili, 2009, "A Literature Review of the Practical Application of Bacteriophage Research", 184 pp.
- ↑ Kuchment, Anna (2011); Häusler, Thomas (2006)
- 1 2 "KERA Think! Podcast: Viruses are Everywhere!". 16 June 2011. Retrieved 4 June 2012. (audio)
- ↑ Mangen MJ, Havelaar AH, Poppe KP, de Wit GA (August 2007). "Cost-utility analysis to control Campylobacter on chicken meat: dealing with data limitations". Risk Analysis. 27 (4): 815–830. Bibcode:2007RiskA..27..815M. doi:10.1111/j.1539-6924.2007.00925.x. PMID 17958494. S2CID 25966489.
- 1 2 Mc Grath S, Sinderen D, eds. (2007). Bacteriophage: Genetics and Molecular Biology (1st ed.). Caister Academic Press. ISBN 978-1-904455-14-1. .
- ↑ Balogh B, Jones JB, Iriarte FB, Momol MT (January 2010). "Phage therapy for plant disease control". Current Pharmaceutical Biotechnology. Bentham Science Publishers. 11 (1): 48–57. doi:10.2174/138920110790725302. PMID 20214607. S2CID 20820594.
- ↑ Wang N, Pierson EA, Setubal JC, Xu J, Levy JG, Zhang Y, et al. (August 2017). "The Candidatus Liberibacter-Host Interface: Insights into Pathogenesis Mechanisms and Disease Control". Annual Review of Phytopathology. Annual Reviews. 55 (1): 451–482. doi:10.1146/annurev-phyto-080516-035513. PMID 28637377. S2CID 207653521.
- 1 2 3 Varani AM, Monteiro-Vitorello CB, Nakaya HI, Van Sluys MA (4 August 2013). "The role of prophage in plant-pathogenic bacteria". Annual Review of Phytopathology. Annual Reviews. 51 (1): 429–451. doi:10.1146/annurev-phyto-081211-173010. PMID 23725471. S2CID 207644125.
- ↑ Soothill JS (June 1994). "Bacteriophage prevents destruction of skin grafts by Pseudomonas aeruginosa". Burns. 20 (3): 209–211. doi:10.1016/0305-4179(94)90184-8. PMID 8054131.
- ↑ McVay CS, Velásquez M, Fralick JA (June 2007). "Phage therapy of Pseudomonas aeruginosa infection in a mouse burn wound model". Antimicrobial Agents and Chemotherapy. 51 (6): 1934–1938. doi:10.1128/AAC.01028-06. PMC 1891379. PMID 17387151.
- ↑ Yacoby I, Bar H, Benhar I (June 2007). "Targeted drug-carrying bacteriophages as antibacterial nanomedicines". Antimicrobial Agents and Chemotherapy. 51 (6): 2156–2163. doi:10.1128/AAC.00163-07. PMC 1891362. PMID 17404004.
- ↑ Yacoby I, Shamis M, Bar H, Shabat D, Benhar I (June 2006). "Targeting antibacterial agents by using drug-carrying filamentous bacteriophages". Antimicrobial Agents and Chemotherapy. 50 (6): 2087–2097. doi:10.1128/AAC.00169-06. PMC 1479106. PMID 16723570.
- ↑ Bar H, Yacoby I, Benhar I (April 2008). "Killing cancer cells by targeted drug-carrying phage nanomedicines". BMC Biotechnology. 8: 37. doi:10.1186/1472-6750-8-37. PMC 2323368. PMID 18387177.
- ↑ "European Medicines Agency – News and Events – Workshop on the therapeutic use of bacteriophages". www.ema.europa.eu. 17 September 2018.
- ↑ "Bacteriophage Therapy: An Alternative Strategy to Combat Drug Resistance". respond.niaid.nih.gov. Archived from the original on 1 July 2016. Retrieved 20 August 2015.
- 1 2 Zimmer C (7 December 2016). "A virus, fished out of a lake, may have saved a man's life – and advanced science". Stat News. Retrieved 30 January 2021.
- ↑ "Genetically Modified Viruses Help Save a Patient With a 'Superbug' Infection". NPR.org.
- ↑ Gallagher J (8 May 2019). "Phage therapy: 'Viral cocktail saved my daughter's life'". BBC News.
- 1 2 Dedrick RM, Guerrero-Bustamante CA, Garlena RA, Russell DA, Ford K, Harris K, et al. (May 2019). "Engineered bacteriophages for treatment of a patient with a disseminated drug-resistant Mycobacterium abscessus". Nature Medicine. 25 (5): 730–733. doi:10.1038/s41591-019-0437-z. PMC 6557439. PMID 31068712.
- ↑ "Phage Therapy Win: Mycobacterium Infection Halted". 8 May 2019.
- 1 2 Nick JA, Dedrick RM, Gray AL, Vladar EK, Smith BE, Freeman KG, et al. (May 2022). "Host and pathogen response to bacteriophage engineered against Mycobacterium abscessus lung infection". Cell. 185 (11): 1860–1874.e12. doi:10.1016/j.cell.2022.04.024. PMC 9840467. PMID 35568033. S2CID 248755782.
- ↑ Little JS, Dedrick RM, Freeman KG, Cristinziano M, Smith BE, Benson CA, et al. (May 2022). "Bacteriophage treatment of disseminated cutaneous Mycobacterium chelonae infection". Nature Communications. 13 (1): 2313. Bibcode:2022NatCo..13.2313L. doi:10.1038/s41467-022-29689-4. PMC 9064978. PMID 35504908.
- ↑ Górski A, Miedzybrodzki R, Borysowski J, Weber-Dabrowska B, Lobocka M, Fortuna W, et al. (August 2009). "Bacteriophage therapy for the treatment of infections". Current Opinion in Investigational Drugs. 10 (8): 766–774. PMID 19649921.
- ↑ "What is Phage Therapy?". phagetherapycenter.com. Retrieved 29 November 2014.
- 1 2 "Phage Therapy: Past History and Future Prospects" (PDF).
- ↑ Abedon ST (2012). Salutary contributions of viruses to medicine and public health. In: Witzany G (ed). Viruses: Essential Agents of Life. Springer. 389–405. ISBN 978-94-007-4898-9.
- ↑ Duckworth DH, Gulig PA (2002). "Bacteriophages: potential treatment for bacterial infections". BioDrugs. 16 (1): 57–62. doi:10.2165/00063030-200216010-00006. PMID 11909002. S2CID 249919919.
- ↑ Zhang S, Chen DC (May 2019). "Facing a new challenge: the adverse effects of antibiotics on gut microbiota and host immunity". Chinese Medical Journal. 132 (10): 1135–1138. doi:10.1097/CM9.0000000000000245. PMC 6511407. PMID 30973451.
- ↑ Choudhury TG, Maiti B, Venugopal MN, Karunasagar I (March 2019). "Influence of some environmental variables and addition of r-lysozyme on efficacy of Vibrio harveyi phage for therapy". Journal of Biosciences. 44 (1). doi:10.1007/s12038-018-9830-x. PMID 30837359. S2CID 59524581.
- ↑ "Scientists Engineer Viruses To Battle Bacteria". NPR.org.
- ↑ Borysowski J, Weber-Dabrowska B, Górski A (April 2006). "Bacteriophage endolysins as a novel class of antibacterial agents". Experimental Biology and Medicine. 231 (4): 366–377. doi:10.1177/153537020623100402. PMID 16565432. S2CID 28367348.
- ↑ Efrony R, Atad I, Rosenberg E (February 2009). "Phage therapy of coral white plague disease: properties of phage BA3". Current Microbiology. 58 (2): 139–145. doi:10.1007/s00284-008-9290-x. PMID 18923867. S2CID 1823011.
- ↑ McCallin S, Alam Sarker S, Barretto C, Sultana S, Berger B, Huq S, et al. (September 2013). "Safety analysis of a Russian phage cocktail: from metagenomic analysis to oral application in healthy human subjects". Virology. 443 (2): 187–196. doi:10.1016/j.virol.2013.05.022. PMID 23755967.
- ↑ Abedon ST, Kuhl SJ, Blasdel BG, Kutter EM (March 2011). "Phage treatment of human infections". Bacteriophage. 1 (2): 66–85. doi:10.4161/bact.1.2.15845. PMC 3278644. PMID 22334863.
- ↑ Villarroel J, Larsen MV, Kilstrup M, Nielsen M (November 2017). "Metagenomic Analysis of Therapeutic PYO Phage Cocktails from 1997 to 2014". Viruses. 9 (11): 328. doi:10.3390/v9110328. PMC 5707535. PMID 29099783.
- ↑ Brüssow H (July 2005). "Phage therapy: the Escherichia coli experience". Microbiology. 151 (Pt 7): 2133–2140. doi:10.1099/mic.0.27849-0. PMID 16000704.
- ↑ Brüssow H (2007). "Phage Therapy: The Western Perspective". In McGrath S, van Sinderen D (eds.). Bacteriophage: Genetics and Molecular Biology. Norfolk, UK: Caister Academic Press. ISBN 978-1-904455-14-1.
- ↑ "Press & News". Archived from the original on 30 November 2007. Retrieved 13 December 2007.
- ↑ "biocontrol.ltd.uk". Archived from the original on 15 April 2009. Retrieved 13 December 2007.
- ↑ "biocontrol-ltd.com". Archived from the original on 26 May 2008. Retrieved 30 April 2008.
- ↑ Wright A, Hawkins CH, Anggård EE, Harper DR (August 2009). "A controlled clinical trial of a therapeutic bacteriophage preparation in chronic otitis due to antibiotic-resistant Pseudomonas aeruginosa; a preliminary report of efficacy". Clinical Otolaryngology. 34 (4): 349–357. doi:10.1111/j.1749-4486.2009.01973.x. PMID 19673983.
- ↑ Rhoads DD, Wolcott RD, Kuskowski MA, Wolcott BM, Ward LS, Sulakvelidze A (June 2009). "Bacteriophage therapy of venous leg ulcers in humans: results of a phase I safety trial". Journal of Wound Care. 18 (6): 237–38, 240–43. doi:10.12968/jowc.2009.18.6.42801. PMID 19661847.
- ↑ Jault P, Leclerc T, Jennes S, Pirnay JP, Que YA, Resch G, et al. (January 2019). "Efficacy and tolerability of a cocktail of bacteriophages to treat burn wounds infected by Pseudomonas aeruginosa (PhagoBurn): a randomised, controlled, double-blind phase 1/2 trial". The Lancet. Infectious Diseases. 19 (1): 35–45. doi:10.1016/S1473-3099(18)30482-1. PMID 30292481. S2CID 52930681.
- ↑ "Scientists Modify Viruses with CRISPR to Create New Weapon Against Superbugs". NPR. 22 May 2019. Retrieved 28 May 2019.
- ↑ Eanes, Zachery (9 March 2021). "Locus using gene-editing technology to get ahead of drug-resistant bacteria". The Herald-Sun. pp. B4. Retrieved 19 August 2022 – via Newspapers.com.
- ↑ Voelker R (February 2019). "FDA Approves Bacteriophage Trial". JAMA. 321 (7): 638. doi:10.1001/jama.2019.0510. PMID 30778586. S2CID 73464136.
- ↑ Clinical trial number NCT04684641 for "CYstic Fibrosis bacterioPHage Study at Yale (CYPHY): A Single-site, Randomized, Double-blind, Placebo-controlled Study of Bacteriophage Therapy YPT-01 for Pseudomonas Aeruginosa Infections in Adults With Cystic Fibrosis " at ClinicalTrials.gov
- ↑ Clinical trial number NCT04287478 for "A Phase I/II Study of Bacteriophage Therapy to Evaluate Safety, Tolerability, and Efficacy of Targeted "Personalized" Bacteriophage Treatments in Patients With Bacterial Infection of the Urinary Tract " at ClinicalTrials.gov
- ↑ Clinical trial number NCT04787250 for "Randomized Open Label, Parallel Group, Controlled Study to Evaluate the Safety and Surgery Sparing Effect of Phage Therapy with Antibiotics for Patients with Prosthetic Joint Infections Who Are Candidates for Two Stage Exchange Arthroplasty " at ClinicalTrials.gov
- ↑ "Novel Phage Therapy Saves Patient with Multidrug-Resistant Bacterial Infection". UC San Diego Health. 25 April 2017.
- ↑ Ghorayshi A (12 November 2018). "This Scientist Used Live Viruses to Save a Woman's Life from a Superbug Infection". Buzzfeed News. Retrieved 30 January 2021.
- ↑ "The 26-year-old who inhaled a virus to fight an antibiotic-resistant superbug". NY Post. 26 February 2019. Retrieved 30 January 2021.
- ↑ "He was going to lose his leg until doctors turned to cure older than dirt". OregonLive.com. Minneapolis Star Tribune. 28 December 2019. Retrieved 28 December 2019.
- ↑ Kahn L (9 October 2018). "Bacteriophages: a promising approach to fighting antibiotic-resistant bacteria". Bulletin of the Atomic Scientists.
- ↑ Schooley RT, Biswas B, Gill JJ, Hernandez-Morales A, Lancaster J, Lessor L, et al. (October 2017). "Development and Use of Personalized Bacteriophage-Based Therapeutic Cocktails to Treat a Patient with a Disseminated Resistant Acinetobacter baumannii Infection". Antimicrobial Agents and Chemotherapy. 61 (10): e00954-17. doi:10.1128/AAC.00954-17. PMC 5610518. PMID 28807909.
- ↑ "Phage therapies for superbug infections are being tested in Belgium". New Scientist. Retrieved 14 February 2022.
- ↑ Eskenazi A, Lood C, Wubbolts J, Hites M, Balarjishvili N, Leshkasheli L, et al. (January 2022). "Combination of pre-adapted bacteriophage therapy and antibiotics for treatment of fracture-related infection due to pandrug-resistant Klebsiella pneumoniae". Nature Communications. 13 (1): 302. Bibcode:2022NatCo..13..302E. doi:10.1038/s41467-021-27656-z. PMC 8766457. PMID 35042848.
- ↑ "Mit Viren gegen Bakterien – Bakteriophagen-Therapie als Hoffnung gegen multiresistente Keime". Deutschlandfunk (in German). Retrieved 14 February 2022.
- ↑ Yirka B. "Using a bacteriophage to successfully treat a patient infected with a drug-resistant bacteria". medicalxpress.com. Retrieved 14 February 2022.
The researchers suggest that bacteriophage therapy is a viable treatment for bacterial infections, though they note that before it can be considered as an alternative therapy for infected patients, a better means of finding bacteriophages must be found.
- 1 2 3 Pires, Diana P; Meneses, Luciana; Brandão, Ana C; Azeredo, Joana (1 April 2022). "An overview of the current state of phage therapy for the treatment of biofilm-related infections". Current Opinion in Virology. 53: 101209. doi:10.1016/j.coviro.2022.101209. ISSN 1879-6257. PMID 35240424. S2CID 247180890.
- 1 2 Uyttebroek, Saartje; Chen, Baixing; Onsea, Jolien; Ruythooren, Fred; Debaveye, Yves; Devolder, David; Spriet, Isabel; Depypere, Melissa; Wagemans, Jeroen; Lavigne, Rob; Pirnay, Jean-Paul; Merabishvili, Maya; De Munter, Paul; Peetermans, Willy E; Dupont, Lieven (1 August 2022). "Safety and efficacy of phage therapy in difficult-to-treat infections: a systematic review". The Lancet Infectious Diseases. 22 (8): e208–e220. doi:10.1016/S1473-3099(21)00612-5. ISSN 1473-3099. PMID 35248167. S2CID 247251901.
- ↑ Hatfull GF (2005). "Mycobacteriophages: Pathogenesis and Applications". In Waldor MK, Friedman DI, Adhya SL (eds.). Phages: Their role in bacterial pathogenesis and biotechnology. ASM Press. pp. 238–55.
- ↑ Verbeken G, De Vos D, Vaneechoutte M, Merabishvili M, Zizi M, Pirnay JP (October 2007). "European regulatory conundrum of phage therapy". Future Microbiology. 2 (5): 485–491. doi:10.2217/17460913.2.5.485. PMID 17927471.
- ↑ Fu W, Forster T, Mayer O, Curtin JJ, Lehman SM, Donlan RM (January 2010). "Bacteriophage cocktail for the prevention of biofilm formation by Pseudomonas aeruginosa on catheters in an in vitro model system". Antimicrobial Agents and Chemotherapy. 54 (1): 397–404. doi:10.1128/AAC.00669-09. PMC 2798481. PMID 19822702.
- 1 2 Pires DP, Dötsch A, Anderson EM, Hao Y, Khursigara CM, Lam JS, et al. (2017). "A Genotypic Analysis of Five P. aeruginosa Strains after Biofilm Infection by Phages Targeting Different Cell Surface Receptors". Frontiers in Microbiology. 8: 1229. doi:10.3389/fmicb.2017.01229. PMC 5492357. PMID 28713356.
- ↑ Le S, Yao X, Lu S, Tan Y, Rao X, Li M, et al. (April 2014). "Chromosomal DNA deletion confers phage resistance to Pseudomonas aeruginosa". Scientific Reports. 4: 4738. Bibcode:2014NatSR...4E4738L. doi:10.1038/srep04738. PMC 4001099. PMID 24770387.
- 1 2 Oechslin F (June 2018). "Resistance Development to Bacteriophages Occurring during Bacteriophage Therapy". Viruses. 10 (7): 351. doi:10.3390/v10070351. PMC 6070868. PMID 29966329.
- ↑ Oechslin F, Piccardi P, Mancini S, Gabard J, Moreillon P, Entenza JM, et al. (March 2017). "Synergistic Interaction Between Phage Therapy and Antibiotics Clears Pseudomonas Aeruginosa Infection in Endocarditis and Reduces Virulence". The Journal of Infectious Diseases. 215 (5): 703–712. doi:10.1093/infdis/jiw632. PMC 5388299. PMID 28007922.
- ↑ Bertozzi Silva J, Storms Z, Sauvageau D (February 2016). "Host receptors for bacteriophage adsorption". FEMS Microbiology Letters. 363 (4): fnw002. doi:10.1093/femsle/fnw002. PMID 26755501.
- ↑ León M, Bastías R (2015). "Virulence reduction in bacteriophage resistant bacteria". Frontiers in Microbiology. 6: 343. doi:10.3389/fmicb.2015.00343. PMC 4407575. PMID 25954266.
- ↑ Chan BK, Sistrom M, Wertz JE, Kortright KE, Narayan D, Turner PE (May 2016). "Phage selection restores antibiotic sensitivity in MDR Pseudomonas aeruginosa". Scientific Reports. 6 (1): 26717. Bibcode:2016NatSR...626717C. doi:10.1038/srep26717. PMC 4880932. PMID 27225966.
- ↑ Labrie SJ, Samson JE, Moineau S (May 2010). "Bacteriophage resistance mechanisms". Nature Reviews. Microbiology. 8 (5): 317–327. doi:10.1038/nrmicro2315. PMID 20348932. S2CID 205497795.
- ↑ Pedersen T, Dutfield S (18 January 2022). "Prokaryotic vs. Eukaryotic Cells: What's the Difference?". livescience.com. Retrieved 15 March 2022.
- ↑ Di Giovine M, Salone B, Martina Y, Amati V, Zambruno G, Cundari E, et al. (March 2001). "Binding properties, cell delivery, and gene transfer of adenoviral penton base displaying bacteriophage". Virology. 282 (1): 102–112. doi:10.1006/viro.2000.0809. PMID 11259194.
- ↑ Nguyen S, Baker K, Padman BS, Patwa R, Dunstan RA, Weston TA, et al. (November 2017). "Bacteriophage Transcytosis Provides a Mechanism to Cross Epithelial Cell Layers". mBio. 8 (6). doi:10.1128/mBio.01874-17. PMC 5698557. PMID 29162715.
- ↑ Sweere JM, Van Belleghem JD, Ishak H, Bach MS, Popescu M, Sunkari V, et al. (March 2019). "Bacteriophage trigger antiviral immunity and prevent clearance of bacterial infection". Science. 363 (6434): eaat9691. doi:10.1126/science.aat9691. PMC 6656896. PMID 30923196.
- ↑ Bruttin A, Brüssow H (July 2005). "Human volunteers receiving Escherichia coli phage T4 orally: a safety test of phage therapy". Antimicrobial Agents and Chemotherapy. 49 (7): 2874–2878. doi:10.1128/AAC.49.7.2874-2878.2005. PMC 1168693. PMID 15980363.
- ↑ Międzybrodzki R, Borysowski J, Weber-Dąbrowska B, Fortuna W, Letkiewicz S, Szufnarowski K, et al. (2012). "Clinical Aspects of Phage Therapy". Bacteriophages, Part B. Advances in Virus Research. Vol. 83. pp. 73–121. doi:10.1016/B978-0-12-394438-2.00003-7. ISBN 9780123944382. PMID 22748809.
- ↑ Speck P, Smithyman A (February 2016). "Safety and efficacy of phage therapy via the intravenous route". FEMS Microbiology Letters. 363 (3): fnv242. doi:10.1093/femsle/fnv242. PMID 26691737.
- ↑ Prins JM, van Deventer SJ, Kuijper EJ, Speelman P (June 1994). "Clinical relevance of antibiotic-induced endotoxin release". Antimicrobial Agents and Chemotherapy. 38 (6): 1211–1218. doi:10.1128/aac.38.6.1211. PMC 188188. PMID 8092816.
- ↑ Pirnay JP, Blasdel BG, Bretaudeau L, Buckling A, Chanishvili N, Clark JR, et al. (July 2015). "Quality and safety requirements for sustainable phage therapy products". Pharmaceutical Research. 32 (7): 2173–2179. doi:10.1007/s11095-014-1617-7. PMC 4452253. PMID 25585954.
- ↑ Sarker SA, Berger B, Deng Y, Kieser S, Foata F, Moine D, et al. (January 2017). "Oral application of Escherichia coli bacteriophage: safety tests in healthy and diarrheal children from Bangladesh". Environmental Microbiology. 19 (1): 237–250. Bibcode:2017EnvMi..19..237S. doi:10.1111/1462-2920.13574. PMID 27750388. S2CID 30583654.
- ↑ McCallin S, Sarker SA, Sultana S, Oechslin F, Brüssow H (September 2018). "Metagenome analysis of Russian and Georgian Pyophage cocktails and a placebo-controlled safety trial of single phage versus phage cocktail in healthy Staphylococcus aureus carriers". Environmental Microbiology. 20 (9): 3278–3293. Bibcode:2018EnvMi..20.3278M. doi:10.1111/1462-2920.14310. PMID 30051571. S2CID 51725081.
- ↑ Sarker SA, McCallin S, Barretto C, Berger B, Pittet AC, Sultana S, et al. (December 2012). "Oral T4-like phage cocktail application to healthy adult volunteers from Bangladesh". Virology. 434 (2): 222–232. doi:10.1016/j.virol.2012.09.002. PMID 23102968.
- ↑ Sarker SA, Sultana S, Reuteler G, Moine D, Descombes P, Charton F, et al. (February 2016). "Oral Phage Therapy of Acute Bacterial Diarrhea with Two Coliphage Preparations: A Randomized Trial in Children from Bangladesh". eBioMedicine. 4: 124–137. doi:10.1016/j.ebiom.2015.12.023. PMC 4776075. PMID 26981577.
- ↑ Galtier M, De Sordi L, Maura D, Arachchi H, Volant S, Dillies MA, Debarbieux L (July 2016). "Bacteriophages to reduce gut carriage of antibiotic resistant uropathogens with low impact on microbiota composition". Environmental Microbiology. 18 (7): 2237–2245. Bibcode:2016EnvMi..18.2237G. doi:10.1111/1462-2920.13284. PMID 26971586. S2CID 22746141.
- ↑ Majewska J, Kaźmierczak Z, Lahutta K, Lecion D, Szymczak A, Miernikiewicz P, et al. (2019). "Induction of Phage-Specific Antibodies by Two Therapeutic Staphylococcal Bacteriophages Administered per os". Frontiers in Immunology. 10: 2607. doi:10.3389/fimmu.2019.02607. PMC 6871536. PMID 31803179.
- ↑ "Phage Therapy: Bacteriophages as Antibiotics". Evergreen. Archived from the original on 2 March 2007.
- ↑ "Stone, Richard. "Stalin's Forgotten Cure." Science Online 282 (25 October 2002)". Archived from the original on 4 July 2008.
- ↑ Fox SI (1999). Human Physiology -6th ed. McGraw-Hill. pp. 50, 55, 448, 449. ISBN 978-0-697-34191-4.
- ↑ Kuchement (2011, p. 94)
- ↑ Kuchement (2011, ch. 6, p. 63): "[T]he Hirszfeld Institute [in Poland] has almost always done its research studies in the absence of double-bind controls ... . But the sheer quantity of cases, combined with the fact that nearly all the cases involve patients who failed to respond to antibiotics, is persuasive."
- ↑ Faltys D (4 August 2013), "Evergreen Researcher Dr. Kutter Announces 'There's a Phage for That'", Thurston Talk, Olympia, Washington, retrieved 1 March 2015
- ↑ Kuchment (2011, ch. 12, pp. 115–18): In addition to mentioning that Texas law allows physicians to use "natural substances" like phages in addition to (but not in lieu of) standard medical practice, Kuichment says, "In June 2009 [Dr. Randall Wolcott's] study was published in the Journal of Wound Care."
- ↑ December 2013 Faculty Spotlight, Olympia, WA: Evergreen College, December 2013, retrieved 1 March 2015
- ↑ Dublanchet A, Fruciano E (August 2008). "[A short history of phage therapy]". Médecine et Maladies Infectieuses. 38 (8): 415–420. doi:10.1016/j.medmal.2008.06.016. PMID 18692974.
- ↑ Verbeken G, Pirnay JP, Lavigne R, Jennes S, De Vos D, Casteels M, Huys I (April 2014). "Call for a dedicated European legal framework for bacteriophage therapy". Archivum Immunologiae et Therapiae Experimentalis. 62 (2): 117–129. doi:10.1007/s00005-014-0269-y. PMC 3950567. PMID 24500660.
- 1 2 Fauconnier A (April 2019). "Phage Therapy Regulation: From Night to Dawn". Viruses. 11 (4): 352. doi:10.3390/v11040352. PMC 6521264. PMID 30999559.
- 1 2 3 Pirnay JP, Verbeken G, Ceyssens PJ, Huys I, De Vos D, Ameloot C, Fauconnier A (February 2018). "The Magistral Phage". Viruses. 10 (2): 64. doi:10.3390/v10020064. PMC 5850371. PMID 29415431.
- ↑ Fauconnier A (February 2017). "Regulating phage therapy: The biological master file concept could help to overcome regulatory challenge of personalized medicines". EMBO Reports. 18 (2): 198–200. doi:10.15252/embr.201643250. PMC 5286392. PMID 28082313.
- ↑ Henein A (April 2013). "What are the limitations on the wider therapeutic use of phage?". Bacteriophage. 3 (2): e24872. doi:10.4161/bact.24872. PMC 3821673. PMID 24228220.
- ↑ McCallin S, Sacher JC, Zheng J, Chan BK (April 2019). "Current State of Compassionate Phage Therapy". Viruses. 11 (4): 343. doi:10.3390/v11040343. PMC 6521059. PMID 31013833.
- ↑ Patey O, McCallin S, Mazure H, Liddle M, Smithyman A, Dublanchet A (December 2018). "Clinical Indications and Compassionate Use of Phage Therapy: Personal Experience and Literature Review with a Focus on Osteoarticular Infections". Viruses. 11 (1): 18. doi:10.3390/v11010018. PMC 6356659. PMID 30597868.
- ↑ Pirnay, J. P.; Verbeken, G.; Ceyssens, P. J.; Huys, I.; De Vos, D.; Ameloot, C.; Fauconnier, A. (6 February 2018). "The Magistral Phage". Viruses. 10 (2): 64. doi:10.3390/v10020064. PMC 5850371. PMID 29415431.
- ↑ Liang, Shuang; Qi, Yanling; Yu, Huabo; Sun, Wuwen; Raza, Sayed Haidar Abbas; Alkhorayef, Nada; Alkhalil, Samia S.; Salama, Essam Eldin Abdelhady; Zhang, Lei (20 February 2023). "Bacteriophage Therapy as an Application for Bacterial Infection in China". Antibiotics. 12 (2): 417. doi:10.3390/antibiotics12020417. ISSN 2079-6382. PMC 9952293. PMID 36830327.
- ↑ Bao, Juan; Wu, Nannan; Zeng, Yigang; Chen, Liguang; Li, Linlin; Yang, Lan; Zhang, Yiyuan; Guo, Mingquan; Li, Lisha; Li, Jie; Tan, Demeng; Cheng, Mengjun; Gu, Jingmin; Qin, Jinghong; Liu, Jiazheng (1 January 2020). "Non-active antibiotic and bacteriophage synergism to successfully treat recurrent urinary tract infection caused by extensively drug-resistant Klebsiella pneumoniae". Emerging Microbes & Infections. 9 (1): 771–774. doi:10.1080/22221751.2020.1747950. ISSN 2222-1751. PMC 7170350. PMID 32212918.
- ↑ Lu, Jiaqi; Xu, Longchang; Wei, Wei; He, Wu (June 2023). "Advanced therapy medicinal products in China: Regulation and development". MedComm. 4 (3): e251. doi:10.1002/mco2.251. ISSN 2688-2663. PMC 10133728. PMID 37125239.
- ↑ Yang, Qimao; Le, Shuai; Zhu, Tongyu; Wu, Nannan (2023). "Regulations of phage therapy across the world". Frontiers in Microbiology. 14. doi:10.3389/fmicb.2023.1250848. ISSN 1664-302X. PMC 10588630. PMID 37869667.
- ↑ Squires RA (December 2021). "Bacteriophage therapy for challenging bacterial infections: achievements, limitations and prospects for future clinical use by veterinary dermatologists". Veterinary Dermatology. 32 (6): 587–e158. doi:10.1111/vde.12958. PMID 33870572. S2CID 233298262.
- ↑ Ferriol-González C, Domingo-Calap P (May 2021). "Phage Therapy in Livestock and Companion Animals". Antibiotics. 10 (5): 559. doi:10.3390/antibiotics10050559. PMC 8150778. PMID 34064754.
- ↑ "Bee Killers: Using Phages Against Deadly Honeybee Diseases". youtube.com. Retrieved 29 November 2014.
- ↑ "Using microscopic bugs to save the bees". news.byu.edu. 20 July 2018. Archived from the original on 11 November 2014. Retrieved 1 December 2014.
- ↑ Stolworthy L (6 May 2016). "BYU's bee team successfully treats honeybee loss". Retrieved 24 September 2018.
- ↑ Richards GP (2014). "Bacteriophage remediation of bacterial pathogens in aquaculture: a review of the technology". Bacteriophage. 4 (4): e975540. doi:10.4161/21597081.2014.975540. PMC 4590005. PMID 26713223.
- 1 2 Nagy J, Király L, Schwarczinger I (25 December 2011). "Phage therapy for plant disease control with a focus on fire blight". Central European Journal of Biology. Versita. 7 (1): 1–12. doi:10.2478/s11535-011-0093-x. ISSN 2391-5412. S2CID 15484075.
- ↑ Summers WC (July 1991). "On the origins of the science in Arrowsmith: Paul de Kruif, Felix d'Herelle, and phage". Journal of the History of Medicine and Allied Sciences. 46 (3): 315–332. doi:10.1093/jhmas/46.3.315. PMID 1918921.
- ↑ "Phage Findings". Time. 3 January 1938. Archived from the original on 13 April 2009. Retrieved 13 December 2007.
- ↑ "SparkNotes: Arrowsmith: Chapters 31–33". Retrieved 13 December 2007.
- ↑ "Churchill the Wartime Feminist". 3 June 2012.
Other resources
- Anomaly, Jonathan (2020). "The Future of Phage". Public Health Ethics. 13 (1): 82–88. doi:10.1093/phe/phaa003. PMC 7392637. PMID 32760449.
- Kulkarni K (2014). The Forgotten Cure: The Past and Future of Phage Therapy. Science India. ISBN 978-1-4614-0250-3.
- Häusler T (2006). Virus vs. Superbug: A solution to the antibiotic crisis?. Macmillan. p. 48. ISBN 978-0-230-55193-0.
External links
- iBiology video: Phage Therapy (2016)
- Elkadi OA (2014). "Phage therapy: The new old antibacterial therapy". El Mednifico Journal. 2 (3): 311. doi:10.18035/emj.v2i3.202.
- Popular Science– "The Next Phage" (2009)
- Thiel K (January 2004). "Old dogma, new tricks–21st Century phage therapy". Nature Biotechnology. 22 (1): 31–36. doi:10.1038/nbt0104-31. PMID 14704699. S2CID 27108321.
- BBC Horizon documentary – The Virus That Cures (1997) at Archive.org
